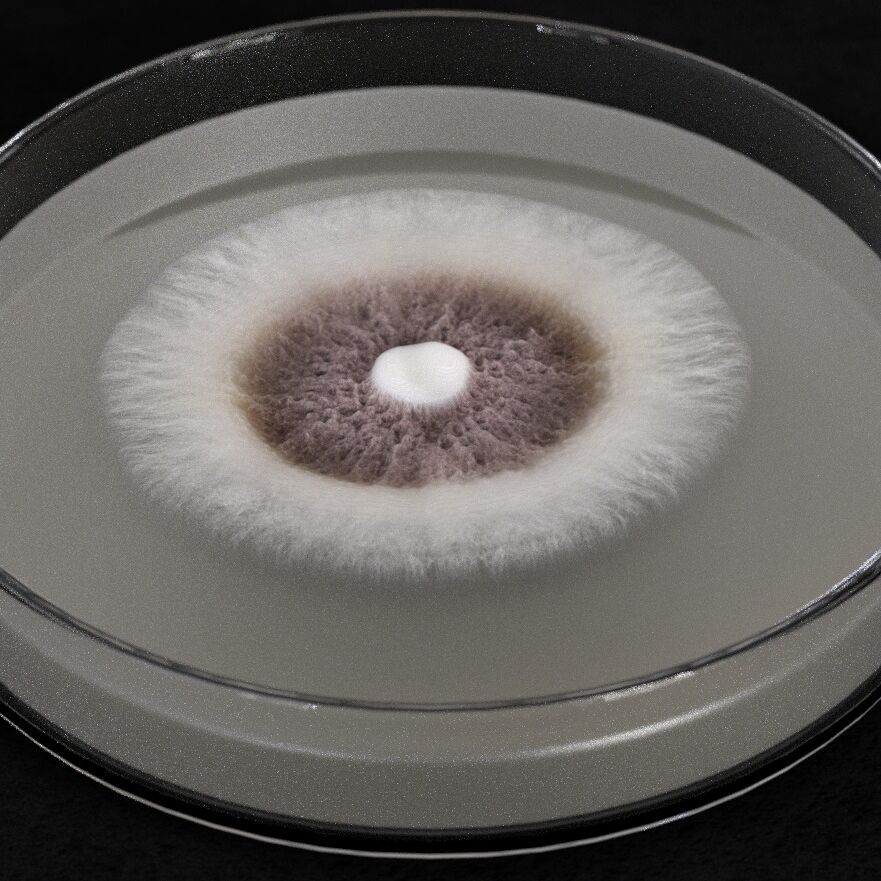

Interceptor
- Isaria fumosorosea
- Beneficial fungi
Testimonials
Downloads
- Jump to: